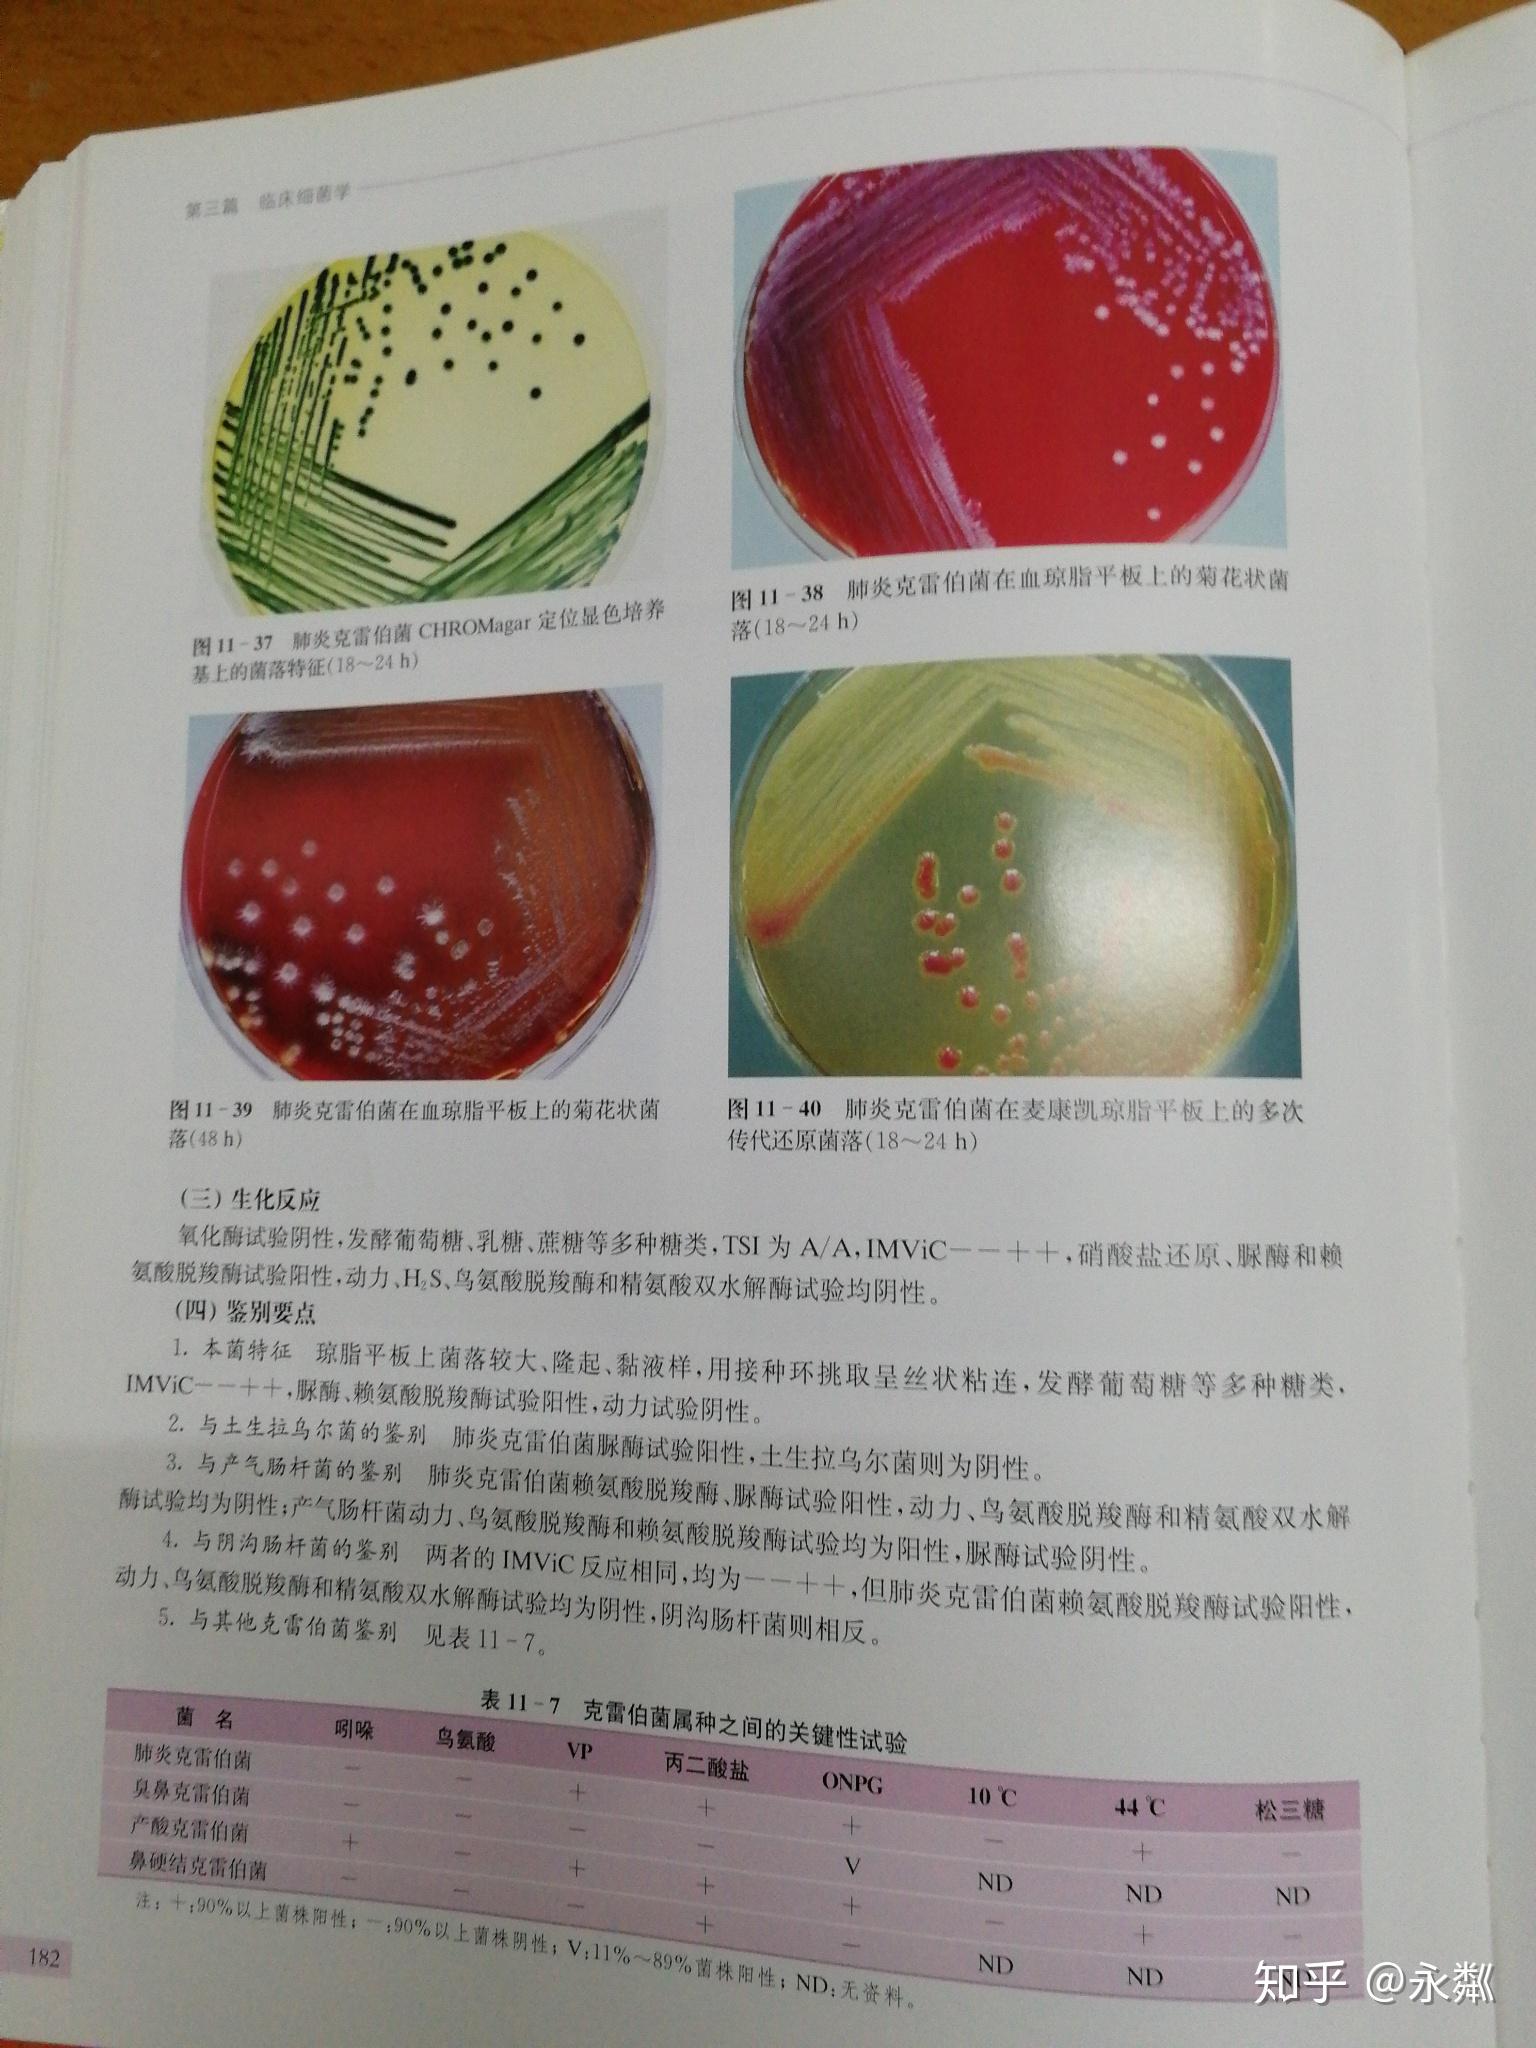
求问哪里能找到菌落颜色大全

常见菌落及颜色

霉菌分类之菌落观察——超清的菌落照片(答案在p7)
图片尺寸950x605
属于葡萄球菌属,革兰氏阳性菌,菌落特征表现为圆形,菌落表面光滑,颜色
图片尺寸1080x1439
各种微生物菌落图,您都分得清吗? - 菲尔德供应链
图片尺寸601x1404
四种颜色的细菌菌落在琼脂平板上,在黑色背景上分离
图片尺寸1106x1100
大肠杆菌菌落及菌体图片
图片尺寸586x745
微生物菌落形态图片
图片尺寸530x525
在tcbs平板上的各种颜色的菌落具体是什么细菌?谢谢
图片尺寸2592x1944
现在才知道,也可以观察菌落颜色
图片尺寸1680x3648
菌落
图片尺寸400x420
原来显微镜下的菌落是那么的美
图片尺寸1080x1441
在tcbs平板上的各种颜色的菌落具体是什么细菌?谢谢
图片尺寸2592x1944
在tcbs平板上的各种颜色的菌落具体是什么细菌?谢谢
图片尺寸2592x1944
大肠杆菌菌落
图片尺寸1944x1438
阴沟肠杆菌鼠伤寒沙门氏菌图3注意事项:选取菌落数在15cfu~150cfu
图片尺寸434x434
在tcbs平板上的各种颜色的菌落具体是什么细菌?谢谢
图片尺寸2592x1944
求问哪里能找到菌落颜色大全
图片尺寸1536x2048
常见微生物菌落形态及消毒灭菌方式汇总
图片尺寸589x441
在琼脂平板上生长的大型霉菌菌落.照片
图片尺寸449x300
试验:阳性卫星实验:阳性灰白色,扁平,中等大小,边缘整齐圆形菌落24 h
图片尺寸508x660
典型霉菌酵母菌菌落形态
图片尺寸465x309